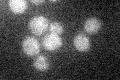
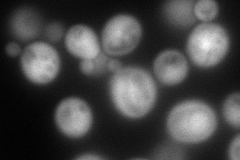
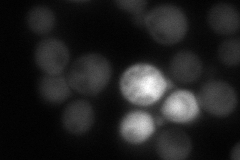
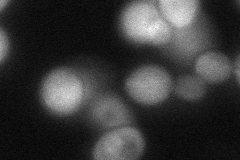
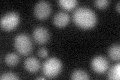

View description
Soluble GTPase with a role in regulation of membrane traffic; regulates potassium influx; G protein of the Ras superfamily, similar to ADP-ribosylation factor
Localization:
Intensity:
Fold change:
Significance:
-
C’ GFP library in SD
below threshold12.69 -
N' NOP1pr-GFP in SD
cytosol188.011 -
N' TEF2pr-mCherry in SD

cytosol,nucleus298.127 -
N' NATIVEpr-GFP in SD
cytosol83.438 -
N' TEF2pr-VC and Cyto-VN in SD
cytosol70.0281 -
C’ GFP library in SD+DTT
cytosol14.261.12No -
C’ GFP library in SD+H2O2

cytosol13.331.04No -
C’ GFP library in Starvation Media

cytosol16.451.29No -
C’ GFP library on the background of Pup2-DaMP

below threshold -
C’ GFP library on the background of CCT mutant

below threshold13.55621.06751No
